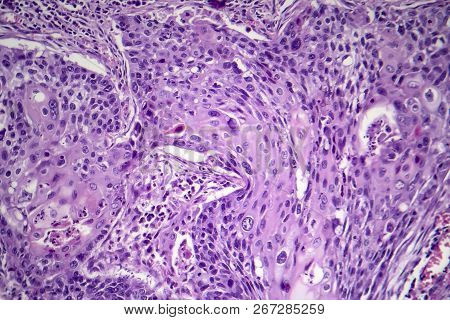
Squamous Cell Carcinoma Of The Lung, Light Micrograph, Photo Under Microscope

Bespaar met Bigstock-abonnementen. Meer informatie >
sluiten
afbeelding
Afbeeldingen
neoplasia
stockfoto's
(Totaal aantal resultaten: 519)